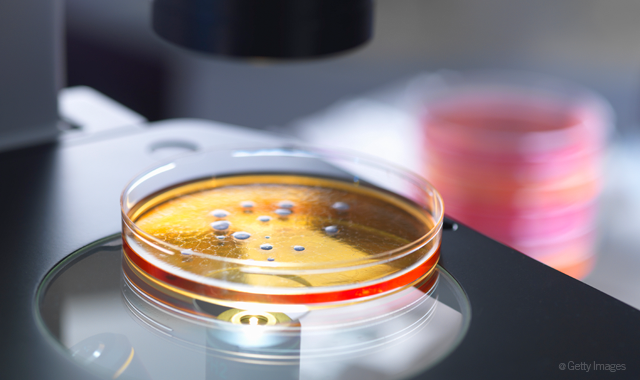

Finding the right disinfectant that's a good fit for your practice is key.
Surface disinfectants are critical products in a dental practice’s infection control efforts. Some are, by nature, better than others. And yet some may simply be more suitable for a given practice based on its work style and demands.

“Finding the disinfectant that is a right ‘fit’ for your practice is important, especially because this is a product that is used so often and there are many considerations,” says Karen Daw of Daw Consulting and former clinic health and safety director for The Ohio State University College of Dentistry.
Read more: How to conduct an infection control risk assessment in your office
There are a few things to be cognizant of when selecting and using a surface disinfectant.
Click through the slides to check out five considerations for surface disinfectants.

Contact time
How long the product remains on the surface to be disinfected is an important consideration because if the product does not remain on the surface – wet – for as long as the manufacturer directs, then it simply has not had enough time to do its job.
More from the author: Why cosmetic dentistry matters to every practice
“Every manufacturer has listed the pathogens their product will inactivate, but the disinfectant requires a minimum amount of contact time in order to be effective,” Daw says. “Some disinfecting products may require multiple wipes each time to meet the requirement. One of the biggest mistakes I see in practices is the use of a disinfectant with a contact time that is longer than the amount of time given to turn over a room. In some cases, the office is aware the time listed is longer but will cut the contact time in order to get the next patient seated. When you don’t allow the product to have contact with the surface for the time indicated, then you might as well be using water because it is not able to do its job and kill pathogens like HIV, hepatitis and TB. The product should be left on according to the longest time listed on the label.”



EPA registration
When assessing a given product, the first place to look is the disinfectant’s label. Key to that is that the product has an EPA registration number. This shows that the product has been independently evaluated according to EPA standards.
“The disinfectant manufacturer must use an approved lab and process to document label kill claims to the EPA,” says Peggy Spitzer, a dental hygienist and clinical education manager for Certol International. “After the EPA reviews and approves, then a registration number is issued.”
Trending article: What you missed at the 2018 Chicago Midwinter Meeting
“Sometimes offices will purchase a product based on cost savings but then I point out that the disinfectant is not registered with the EPA,” Daw adds. “The CDC’s Guidelines for Infection Control in Dental Health-Care Settings - 2003 specifically include the use of an EPA-registered product. In addition, if the surface is contaminated with blood or body fluids, the disinfectant must also have a tuberculocidal claim.”
The TB kill claim, also present on the label, is based on the EPA registration
“TB is spread in the air and it’s not really on surfaces,” Spitzer explains, “but it is hard to kill and is a useful benchmark to indicate that the product is strong enough to kill a broad spectrum of the most common pathogens, including bloodborne organisms found in dental settings.”



Cleaning capability
In order for products to disinfect, they must also clean. The ability of a product to clean is another element when selecting a surface disinfectant.
“Cleaning is not very glamorous, but they cannot kill germs without removing dirt and soils first,” Spitzer says. “Dentistry is a dirty business. There’s a lot of aerosols with soils that are not easy to see, including fine mists of saliva and blood. So whether we see large amounts of soil or not, there definitely is a large amount of soil in the dental environment. Even an oral exam involves spraying air and water into the patient’s mouth, which creates a 3- to 6-foot zone of aerosols on the objects in the patients’ immediate vicinity. This creates the dual challenge to remove soil in addition to killing the germs.”
Related reading: 5 reasons you need an infection prevention coordinator
Cleaning ability is not measured or certified by the EPA, but there are some things the clinician should look for in the products.
“Effective cleaning properties in the formula typically require some water content or other ingredients such as detergent surfactants that really clean, not just kill,” Spitzer explains.
“And this is where it puts a little pressure on the consumer because manufacturers can make cleaning claims on the label with no required testing. It can be EPA-registered, but the EPA does not review cleaning claims -- they only review kill claims.”
Spitzer advises several methods to identify a product’s cleaning abilities.
“Water and detergents are good cleaners but have low toxicity so they may not be listed on the label or the safety data sheet,” she says. “The manufacturer may use terms such as ‘water-based’ or ‘surfactant’ in marketing materials. The product doesn’t have to have water, but it is helpful.
“Quaternary ammoniums (or ‘quats’) are chemicals used in many disinfectants,” she continues. “Quats are not essential, but they do have natural cleaning properties.”
Since interpreting the label can be difficult - and there are no federal mandates for cleaning properties - it comes down, largely, to trial and error when comparing products’ cleaning abilities.
“This is where the customer needs to ask questions of the distributor or manufacturers,” Spitzer says. “They may need to get samples and try different products to see first-hand what cleans in their environment.”



Material compatibility vs. speed
Unfortunately, some products are not suitable for certain equipment. Material compatibility is extremely important to ensure a long use life for the equipment.
Determining which products are appropriate for the practice’s equipment requires some research and study.
“Like cleaning, it’s a little tricky for the average clinician,” Spitzer says. “They know what’s important. They know they want something that doesn’t damage equipment. The place to start are the instructions from the device or dental unit manufacturer. Device and chair manufacturers have frequently tested different formulas and brands on the equipment and will offer recommendations in terms of ‘avoid this chemical’ or ‘use this type of chemical.’
More from the author: What 2018 means for insurance coding
They need to look in the manufacturer’s instructions to find out what items they suggest in terms of ‘use this,’ ‘don’t use this.’ Because, typically, with more expensive equipment, they’ve tested a few different things.”
The potential for damage has stemmed from disinfectant manufacturers’ efforts to meet market demand – namely, speed.
“We’ve kind of shot ourselves in the foot with our pursuit of speed because in order to make products faster, they have to add more chemicals,” Spitzer says. “In order for the disinfectant to get down to one minute, we typically have to add more to it to make it kill faster. In adding these chemicals, it’s made it more challenging to maintain equipment in good condition. It doesn’t mean that we can stop disinfecting; we have to clean and kill, but we are destroying our equipment in order to be fast.”
One easy solution Spitzer recommends is to wipe chemicals off with damp paper towels at the end of every work day.
A resource she recommends is the Organization for Safety, Asepsis and Prevention (OSAP). OSAP is a growing community of clinicians, educators, researchers and industry representatives who advocate for safe and infection-free delivery of oral healthcare.



Read the label
Ultimately, whatever product the practice selects should be used in strict accordance with the manufacturer’s instructions for use.
“Follow manufacturer’s instructions regarding what chemicals should and should not be used to wipe down sensitive equipment in the office,” Daw advises. “Some disinfectants can cause corrosion of sterilizers or X-ray heads. Other products should not be used on chairs or air/water lines because they can advance discoloration. And some products can scratch plastics like eyewear or leave a film on surfaces. Check with the manufacturer for compatibility and ask for suggestions if you notice the product is causing damage. The label also lists appropriate personal protective equipment for use with the product. In the presence of blood, a mask, gown, eye protection and gloves should be worn.”
Trending article: What a paperless practice really looks like
While there are several traits to look for on a product’s label, it may come down to doing one’s homework and sampling a few candidates.
“Try a few products to find the right fit,” Daw advises. “Ask your dental sales representative or reach out to the company directly for samples. Find a disinfectant that meets CDC recommendations, has a contact time that allows the team to turn over the operatory in a timely manner, is compatible with a variety of surfaces and has a pleasant odor. Your team, your patients and your pocketbook will thank you.”
